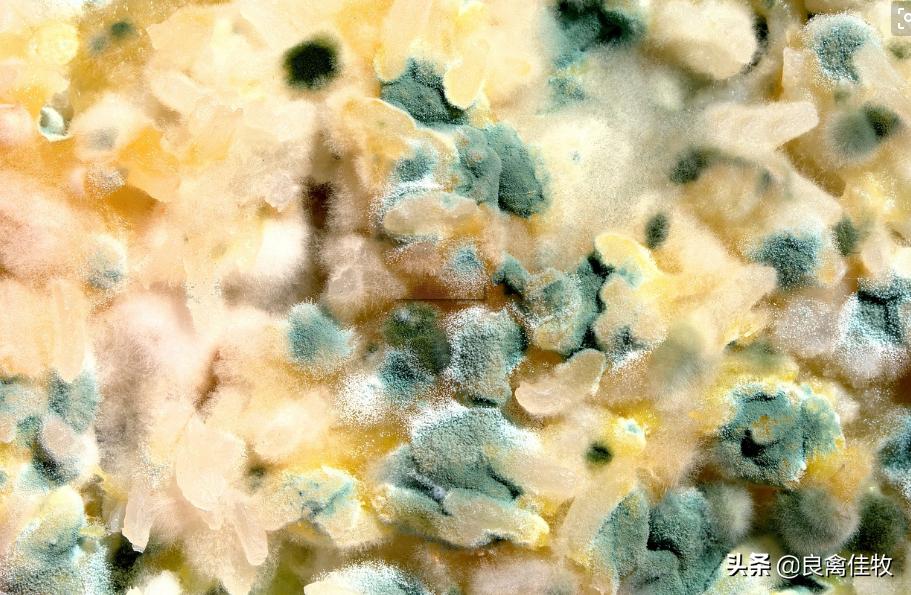
鸡有肠炎可以喂脱霉剂吗,鸡霉菌性肠炎用脱霉剂

现在养殖业处于低谷期,但是鸡子的多种问题也接踵而来,今天肠炎,明天腺胃炎、后天又有呼吸道、养殖户也找不出问题,没有观察是不是自己的饲养管理出现了问题,霉菌能引发鸡子上呼吸道感染和肠炎的高发。由于霉菌的生活空间很广,生活条件很随便,不论在寒冷的冬季,还是在炎热的夏季都可以发现霉菌的广泛分布。各种霉菌其所产生的毒素也各有不同,在炎热的南方和夏天黄曲霉毒素、烟曲毒素比较常见,而在寒冷的北方和冬季多见呕吐毒素、玉米赤霉烯酮,而赭曲毒素、T-2毒素等在南北方均可见到。所以说霉菌及毒素中毒不是我们认为的季节性疾病,而是一年四季都存在的。

霉菌是一种有菌丝形成的真菌,分布相当广泛,各种环境中都可发现,几乎所有禽类都能感染,发病率高,可造成大批死亡。 雏禽对霉菌最容易感染,常是急性暴发。成年家禽个别发生。出壳后的幼雏在进入被烟曲霉菌污染的育雏室后48小时,开始发病亡,4~12日龄是流行高峰期,此后逐渐减少。 雏鸡精神不振,食欲减退,懒动,常缩颈呆立,集聚成堆,畏寒,羽毛粗乱,无光泽,排出水样稀粪或褐色稀粪。
临床症状
1、鸡群食欲基本正常或稍微减退,表现“钩料”症状。(使用小肠球虫药,基本没有效果)
2、鸡群出现较多体重减轻、消瘦的症状,发病鸡只的冠部发白、变薄、鸡冠歪倒。
3、拉黑色糊状粪便,消化不良的饲料样粪便,水样粪便或因继发感染新城疫时出现的黄绿色粪便。

剖检变化
1、嗉囔里充满酸臭液体,内表面附着白色渗出物。
2、腺胃肿胀,严重的出现溃烂,腺胃乳头不同程度出血,肌胃角质层有黄色溃疡线,严重的形成溃疡灶或溃疡斑,腺肌胃交界处溃烂出血
3、肝脏肿大、发黄,有出血点、出血斑或表现出不同程度白色、灰白色坏死点(斑)。
4、脾脏轻微肿大,表面有坏死点(斑),肾脏肿大发红,尿酸盐沉积,严重的表现花斑肾(和肾传支相似)。
5、有气囊炎症状,即气囊混浊,有干酪物,严重的可在干酪物上发现明显的霉菌结节。
治疗方案
(一)预防保健方案:
1、饲养管理 保证饲料原料质量每天要净槽一次舍内湿度不要过高勤消毒(环境, 水线等)及时清理粪便 2、药物治疗
用腺胃炎的专用药【胃得乐】用四天,再搭配霉菌专用药【天下无霉】长期用,有保肝护肾、去除湿气的功效。
天下无霉—让天下畜禽不再受霉菌困扰【主要成分】: 牛磺酸、葡萄糖氧化酶、霉菌毒素分解酶等
【产品功效】:1、能够快速有效吸附和降解黄曲霉毒素、玉米赤霉烯酮、赭曲霉毒素、麦角毒素、呕吐毒素等多种霉菌毒素,使饲料中的霉菌毒素不被机体吸收,迅速排出体外;2、能够快速的渗透入血液显著降低动物血液中及靶器官中霉菌毒素浓度,降低霉菌毒素的毒性;3、解除霉菌毒素对免疫器官功能的抑制,保护肝,肾等重要代谢器官免受霉菌毒素侵害;4、预防和辅助治疗鸡及各种禽类因霉菌毒素中毒如:死淘率增加、生长缓慢,羽毛粗乱,大小不一,久治不愈的拉稀,消瘦。肉禽表现出栏时间延长,料肉比高。蛋禽不断出现零星伤亡或反复拉稀,产蛋率低,蛋品质差,高峰期短。无论肉禽还是蛋禽都可见病禽肝脏发黄,易碎,肿大,肌腺胃出现糜烂,溃疡。